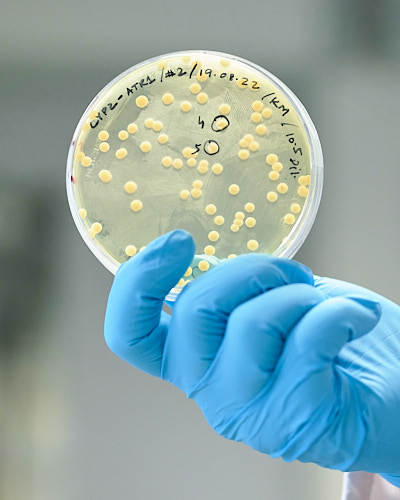

Wissenschaftsfotografie für Universitäten, Labore und Museen
Dokumentarische Fotografie in Forschung und Wissenschaftskommunikation





Dokumentarische Fotografie für Forschung und Wissenschaftskommunikation
Meine Leistungen als Wissenschaftsfotograf
Meine Leistungen als Wissenschaftsfotograf
Laborfotografie und Forschungsdokumentation
Ein Großteil wissenschaftlicher Arbeit findet in spezialisierten Umgebungen statt: in Laboren, Werkstätten oder im Gelände. Ich fotografiere Forschungsprozesse, Arbeitsabläufe und Exkursionen direkt vor Ort. Dabei entstehen nicht nur spannende Momentaufnahmen, sondern auch bemerkenswerte Einblicke in Ihre Forschungsaktivitäten. Meine Fotos eignen sich optimal für Publikationen, Forschungsberichte und die Wissenschaftskommunikation von Instituten und Forschungseinrichtungen.
Laborfotografie und Forschungsdokumentation
Ein Großteil wissenschaftlicher Arbeit findet in spezialisierten Umgebungen statt: in Laboren, Werkstätten oder im Gelände. Ich fotografiere Forschungsprozesse, Arbeitsabläufe und Exkursionen direkt vor Ort. Dabei entstehen nicht nur spannende Momentaufnahmen, sondern auch bemerkenswerte Einblicke in Ihre Forschungsaktivitäten. Meine Fotos eignen sich optimal für Publikationen, Forschungsberichte und die Wissenschaftskommunikation von Instituten und Forschungseinrichtungen.
Universitäts- und Hochschulfotografie
Für Website-Relaunches, Studienmarketing und Institutsseiten benötigen Hochschulen und Universitäten vielseitiges Bildmaterial. Ich veranschauliche als Wissenschaftsfotograf Lehrveranstaltungen, Forschungssituationen und den Campusalltag mit realen Eindrücken von Seminaren, Gruppenarbeiten und Lernsituationen. Ergänzend entstehen Porträts von Mitarbeitenden und Forschungsgruppen sowie Raum- und Gebäudeaufnahmen, die Ihre Einrichtung auf Personal- und Kontaktseiten visuell konsistent darstellen.
Universitäts- und Hochschulfotografie
Für Website-Relaunches, Studienmarketing und Institutsseiten benötigen Hochschulen und Universitäten vielseitiges Bildmaterial. Ich veranschauliche als Wissenschaftsfotograf Lehrveranstaltungen, Forschungssituationen und den Campusalltag mit realen Eindrücken von Seminaren, Gruppenarbeiten und Lernsituationen. Ergänzend entstehen Porträts von Mitarbeitenden und Forschungsgruppen sowie Raum- und Gebäudeaufnahmen, die Ihre Einrichtung auf Personal- und Kontaktseiten visuell konsistent darstellen.
Museumsfotografie und Ausstellungsdokumentation
Museen vermitteln Wissen und kulturelles Erbe auf anschauliche Weise. Meine Museumsfotografie unterstützt diese Arbeit, indem sie Ausstellungen und Objekte plastisch und in ihrem Kontext präsentiert. Dank einer natürlichen Lichtsetzung entstehen atmosphärische Bilder mit realistischer Farbwiedergabe. Bei Gebäude- und Raumansichten lege ich Wert auf realistische Maßstäbe ohne verzerrte Proportionen. Fotos hinter den Kulissen gewähren spannende Einblicke in den Museumsbetrieb. So wird Ihr Ort auch digital authentisch erlebbar.
Museumsfotografie und Ausstellungsdokumentation
Museen vermitteln Wissen und kulturelles Erbe auf anschauliche Weise. Meine Museumsfotografie unterstützt diese Arbeit, indem sie Ausstellungen und Objekte plastisch und in ihrem Kontext präsentiert. Dank einer natürlichen Lichtsetzung entstehen atmosphärische Bilder mit realistischer Farbwiedergabe. Bei Gebäude- und Raumansichten lege ich Wert auf realistische Maßstäbe ohne verzerrte Proportionen. Fotos hinter den Kulissen gewähren spannende Einblicke in den Museumsbetrieb. So wird Ihr Ort auch digital authentisch erlebbar.
Warum Wissenschaftsfotografie sinnvoll ist
Professionelle Wissenschaftsfotografie
- macht Forschung und Lehre greifbar
- übersetzt komplexe Inhalte in verständliche Bilder
- stärkt die Kommunikation mit Öffentlichkeit und Stakeholdern
- illustriert Website, Pressearbeit und Publikationen
- liefert langfristig nutzbares Bildmaterial
- dokumentiert Projekte und Entwicklungen nachhaltig

Mein Ansatz als Wissenschaftsfotograf

Ihre Vorteile einer Zusammenarbeit
Persönliche Handschrift
Authentische Wissenschaftsbilder statt inszenierter Symbolfotos für eine glaubwürdige visuelle Vermittlung.
Einheitliches Design
Konsistente Wissenschaftsfotografie für Website, Publikationen und PR dank stilsicherer Bildgestaltung.
Unkomplizierter Projektablauf
Strukturierte Umsetzung Ihrer Wissenschaftsfotografie von der Konzeption bis zur fertigen Bilddatei.
Vollständige Nutzungsrechte
Flexible Nutzung Ihrer Wissenschaftsfotos und rechtliche Sicherheit durch umfassende Nutzungsrechte.
Fair kalkulierte Preise
Transparente Angebote und individuell abgestimmte Preise für wissenschaftliche Fotoprojekte.
Datensichere Übergabe
Sichere Bereitstellung Ihrer Bilddaten über DSGVO-konformen Downloadlink mit eigener Kundengalerie.
Angebot in 24 Stunden
Schnelle Rückmeldung mit flexibler Planung für kurzfristige oder langfristige Fotoprojekte.
Renommierte Fachausbildung
Dokumentarblick mit wissenschaftlichem Verständnis durch Ausbildung in Fotojournalismus und Geografie.

So läuft eine Zusammenarbeit ab
Anfrage
Sie schildern Ihr Vorhaben und erhalten ein unverbindliches Angebot.
Besprechung
Wir klären Inhalt, Dauer und Ziel der fotografischen Begleitung.
Fotografie vor Ort
Ich begleite Ihre Arbeit situativ und aufmerksam.
Bildbearbeitung
Die Fotos werden professionell aufbereitet.
Bereitstellung
Sie erhalten Ihre Bilder über einen DSGVO-konformen Downloadlink.
Anfrage
Sie schildern Ihr Vorhaben und erhalten ein unverbindliches Angebot.
Besprechung
Wir klären Inhalt, Dauer und Ziel der fotografischen Begleitung.
Fotografie vor Ort
Ich begleite Ihre Arbeit situativ und aufmerksam.
Bildbearbeitung
Die Fotos werden professionell aufbereitet.
Bereitstellung
Sie erhalten Ihre Bilder über einen DSGVO-konformen Downloadlink.
Professionelles Angebot in 24 Stunden
Wissenschaftsfotografie in Deutschland, Österreich und der Schweiz

Über mich
Fortschritt
sichtbar machen

Stimmen zufriedener Kunden
Ich habe Christian durch meine Arbeit als Entspannungspädagogin kennengelernt und bin so auf seine Arbeit aufmerksam geworden. Die Besprechung meiner Wünsche und die Terminfindung liefen super unkompliziert und einfach.
Sonja Machurig
Relaxed And HumanIch habe Christian damit beauftragt, Porträt- und Materialfotos für meine Unternehmenswebseite anzufertigen. Die Fotos sind echt schön geworden und wurden auch super schnell bearbeitet und geliefert.
Anna Volkmar
Therapie durch KunstChristian verstand es, bei der Arbeit die Personen auf seinen Fotos bestmöglich in Szene zu setzen und für seine Fototermine zu begeistern, sodass alle große Freude an der Arbeit hatten.
Dr. Janine Bittner
Universität GöttingenChristian ist kreativ, hat immer das Ganze im Blick und ist sehr gut organisiert. Ein Brainstorming mit ihm führt zu Ergebnissen, die die Dinge auch von anderen Seiten betrachten. Seine Arbeit ist immer einwandfrei, vor allem aber auch zügig.
Stefan Dammann
Weser-KurierAls sehr angenehm empfanden wir auf persönlicher Ebene außerdem seinen respektvollen, kommunikativen und freundlichen Umgang gegenüber Vorgesetzten, Fotomodels und Mitarbeitern.
Prof. Dr. Martin Koch
Universität MarburgHäufige Fragen zur Wissenschaftsfotografie
Was kostet Ihre Wissenschaftsfotografie?
Müssen Szenen gestellt werden?
Wofür können die Fotos genutzt werden?
Können wir die Bildauswahl selbst treffen?
Welche Nutzungsrechte erhalten wir?